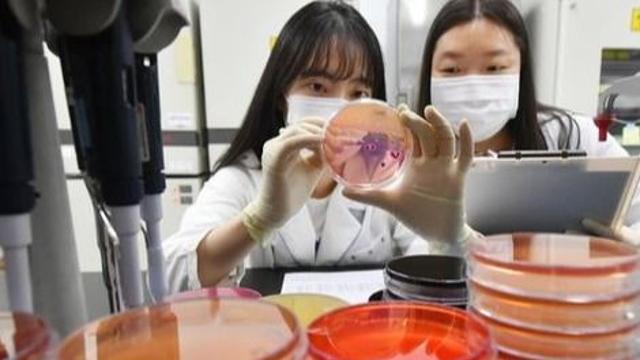
thumbimg

사건사고
- “권성동에 쇼핑백 전달” 일부 인정…한학자 구속영장
- 이데일리 2025.09.18
- [이데일리 김미경 기자] 김건희 특검팀(특별검사 민중기)이 18일 권성동 국민의힘 의원에게
- 김건희, 구속 한달여 만에 병원에...휠체어 타고 진료실로
- 경기일보 2025.09.18
- 최근 서울 동작구의 한 대형병원에서 김 여사가 휠체어를 탄 채 직원의 보조를 받으며 진료실
- 채팅앱서 만난 초등생 '실종자매' 부산으로 데려간 50대 남성
- 이데일리 2025.09.18
- [이데일리 채나연 기자] 채팅 앱을 통해 알게 된 어린 자매를 자신의 차량에 태워 부산으로
- 특검, 통일교 한학자 총재 구속영장·22일 심사…“권성동 세뱃돈”(종합2보)
- 연합뉴스 2025.09.18
- "증거인멸 우려" 바로 신병확보 시도…정치자금법 위반 등 혐의 조사서 "권성동에 세뱃돈 줬
- 속보 19일 새벽 이수고가 일대 정밀안전점검 실시···차량 우회 ‘필요’
- 투데이코리아 2025.09.18
- 투데이코리아=이지형 기자 | 서울 동작구가 이수고가 일대에서 정밀안전점검을 실시한다. 구는
- 권성동 구속 후 첫 특검 조사 3시간 만에 종료…내일 재소환(종합)
- 연합뉴스 2025.09.18
- '정교일치' 의혹 전반·교단 자금 추가 수수 여부 추궁 영장심사 후 이동하는 권성동 의원
- '댓글 조작 의혹' 리박스쿨 대표 구속심사…'묵묵부답'(종합)
- 모두서치 2025.09.18
- 사진 = 뉴시스 제21대 대선을 앞두고 댓글 조작 의혹 등으로 논란이 된 보수 성향 교
- 인명구조견 '대찬', 도랑에 빠진 실종 70대 극적 구조
- 모두서치 2025.09.18
- 사진 = 뉴시스 경기 연천군에서 실종된 70대 노인이 인명구조견 '대찬'에게 발견돼 무
- '통일교 로비' 한학자 총재 구속영장…'실세' 정원주도(종합)
- 모두서치 2025.09.18
- 사진 = 뉴시스 통일교의 윤석열 정권에 대한 '조직적 로비 의혹'의 최종 의사결정권자로
- 잇따른 식중독 소식에 식약처 “명절 귀성길 음식 섭취 및 보관 유의해야”
- 투데이코리아 2025.09.18
- ▲경기 수원시 권선구 경기도보건환경연구원에서 연구원들이 식중독균 배양분리작업을 하고 있다.
- 검찰, 상품권으로 143억원 세탁한 30대 남성 구속 기소
- 모두서치 2025.09.18
- 사진 = 뉴시스 가짜 상품권 업체를 설립해 보이스피싱 일당의 범죄수익금을 은닉한 30대
- 강원도 연이은 비 소식에 강릉 저수율 23% 회복···광동댐은 가뭄 ‘주의’
- 투데이코리아 2025.09.18
- ▲ 오랜 가뭄으로 인해 계곡물이 줄어 바닥이 드러났다. 사진=투데이코리아 투데이코리아=김시
- 통일교, 한학자 구속영장에 "종교 지도자 탄압…참담"
- 모두서치 2025.09.18
- 사진 = 뉴시스 세계평화통일가정연합(통일교)은 윤석열 정권에 대한 로비 의혹으로 한학자
- 전국 다니며 '휴대폰, 모조품으로 바꿔치기' 20대 구속 송치
- 모두서치 2025.09.18
- 사진 = 뉴시스 충북 청주청원경찰서는 전국을 다니며 상습적으로 물건을 훔친 혐의(절도)
- 초등생 실종자매 부산으로 데려간 50대 '실형'…쌍방항소
- 모두서치 2025.09.18
- 사진 = 뉴시스 채팅앱을 통해 알게 된 초등생 실종 자매를 자신의 차량에 태워 경남 김
- 현직 수원시의원, 공직선거법 위반 불구속 송치
- 경기일보 2025.09.18
- 수원장안경찰서. 수원장안경찰서 제공 현직 수원특례시의회 의원이 지역구 주민들에게 식사를
- 'KT 무단 소액결제' 40대 중국 교포 2명 구속..."도망 우려"
- 경기일보 2025.09.18
- KT 무단 소액결제 사건의 피의자인 중국 국적 남성 A씨(왼쪽)와 B씨가 18일 구속 전
- ‘BMW 신차 출고 후’ 트렁크에 수리 흔적이?
- 일요시사 2025.09.18
- [일요시사 취재2팀] 김준혁 기자 = 신차로 인수해 운행하던 BMW 차량에서 출고 전 수리
- 사실혼 여성 살해…4시간 대치한 50대 남성, 징역 25년
- 이데일리 2025.09.18
- [이데일리 이재은 기자] 흉기와 렌터카를 준비해 사실혼 관계인 여성을 살해하고 도주한 뒤
- 특검, '통일교 청탁' 한학자 총재 조사 다음날 전격 구속영장(종합)
- 연합뉴스 2025.09.18
- "증거인멸 우려" 바로 신병확보 시도…정치자금법 위반·횡령 등 혐의 통일교 "국제 종교 지

비즈니스 포커스
주시윤 케어디렉터, 부산 해운대구 반송동 케어허브에서 시니어 복지의 새로운 길을 ...
김지훈 / 25.11.01

경기
광주시 청소년상담복지센터, ‘2025 청소년 마음건강 포럼’ 성료
김기보 / 25.10.31

사회
진천군, 청년 톡톡(Talk Talk) 소통 릴레이 이어져
김영란 / 25.10.31

전북
전북특별자치도소방본부, 무주에 53m급 고가사다리차 배치…고층건축물 화재 대응 강...
김예빈 / 25.10.31